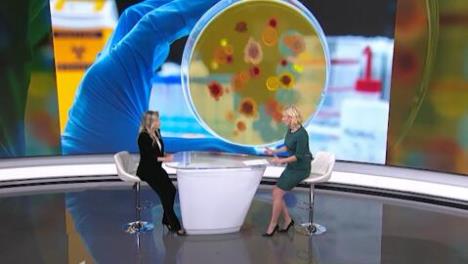
screenshot-71.jpg

POOŠTRIO MERE NADZORA ZBOG MALIH BOGINJA! Ana Banko: Imaćemo veći broj slučajeva malih boginja, a evo ko je NAJUGROŽENIJI

Zbog potvrđenih prvih slučajeva malih boginja, Zavod za javno zdravlje Požarevac prijavio je epidemiju u Smederevu, a Institut "Batut" pooštrio mere nadzora.
Profesorka Medicinskog fakulteta u Beogradu Ana Banko rekla je za RTS da će u Srbiji sigurno biti zabeležen veći broj slučajeva, pošto je broj imunizovanih mali, a da su najugroženija deca do pete godine starosti.
Virusolog Instituta za mikrobiologiju Medicinskog fakulteta u Beogradu profesorka Ana Banko rekla je za RTS da patogeni, koji nisu eliminisani, uvek strpljivo čekaju svoju priliku.
"Za sve one patogene koji nisu eliminisani, a samo je to slučaj sa variolom verom, sa virusom koji je izbačen ili eliminisan iz humane populacije zahvaljujući uspešnom programu imunizacije, svi ostali, koliko god ih možda malo bilo, za neke smo smatrali da ih nema, sve do onog trenutka dok ne proglasimo njihovu eradikaciju, dok postoje u najmanjem ćošku humane populacije, naći će svoj put onda kada mu to dozvolimo", rekla je profesorka Banko.
Istakla je da je poznato da su male boginje jedna od najzaraznijih infektivnih bolesti i da je to infekcija koju smo često poredili kao maksimum koji možemo izvlačiti kao primer u infektivnosti.
"To znači da zaražena osoba sa malim boginjama tu infektivnu bolest može preneti na čak 12 do 18 lica u svojoj sredini, odnosno na devet od deset neimunizovanih ljudi. Zbog toga je neophodan obuhvat vakcinacije i imunizacije za kolektivni imunitet preko 95 posto, a mi smo dugo godina iza toga", navela je profesorka.
"Male boginje u dečjem uzrastu imaju višu stopu komplikacija"
Napomenula je da ova bolest, za razliku od drugih bolesti u dečjem uzrastu, ima višu stopu komplikacija i smrtnih ishoda.
"Zbog čega je u periodu između 2000. i 2017. godine kada je program imunizacije na globalnom nivou tekao po približno standardima kakvim je planirano, pad incidencije, odnosno stope malih boginja i oboljevanja je bio preko 80 posto. Kada su preračunali, praktično, u periodu od 2000. do 2018. godine, verovali ili ne, spašeno je preko 21 milion dečjih života zahvaljujući imunizaciji", naglasila je profesorka Banko.

Dodala je da je obuhvat vakcinacijom posle 2017. godine, a naročito u vreme pandemije koronavirusa, značajno pao u velikom broju zemalja i u Srbiji, pa je epidemija koja započinje u našoj zemlji nešto što je bilo očekivano.
"Sigurno ćemo imati veći broj slučajeva, jer je broj imunizovanih mali. Ja bih samo ovde naglasila da su suštinski najugroženija deca do pete godine starosti, a pre svega, ovde ću podvući da postoje deca koja ne mogu da se vakcinišu zbog primarnih bolesti i deca koja zbog svog uzrasta nisu još stigla na program imunizacije i oni su suštinski najugroženiji", objasnila je Ana Banko.
"Srbija nije izolovan slučaj podložnosti teorijama zavera"
Profesorka Banko je, odgovarajući na pitanje o nepoverenju prema lekarima i medicini, napomenula da zapravo, kad god smo bolesni mi ili naša deca, odlazimo kod lekara, a ne kod komšinice kojoj smo možda više verovali.
"Srbija nije izolovan slučaj podložnosti teorijama zavera i dezinformacijama. Mislim da svi zajedno treba da radimo na edukaciji, na zdravstvenom prosvećivanju. Više znanja povlači za sobom razumevanje, ne samo za program imunizacije, nego uopšte za očuvanje zdravlja kao takvog. Nema mesta za pogrešna pitanja i ja uvek kažem, dok god postoje pitanja, vrata su otvorena za sve one koji žele da razumeju, a takvih ljudi je najviše. Najviše ljudi sa dilemama, sa strahom. Mali je procenat ljudi koji apsolutno zatvaraju vrata i ne žele ništa što nije vezano za nauku i medicinu", naglasila je profesorka.

"Komplikacije ozbiljne i za decu i za odrasle"
Govoreći o malim boginjama, profesorka Ana Banko je rekla da komplikacije mogu da budu ozbiljne i za malu decu i odrasle.
"Komplikacije mogu da budu češće nego kod drugih bolesti u dečjem periodu. One podrazumevaju upalu pluća, odnosno pneumoniju, zapaljenje uha, imunodeficijencije, odnosno probleme sa imunitetom koji kasnije dovode do težeg oboljevanja od drugih infekcija, neurološke ispade, slepilo, konačno zapaljenje mozga i ono što se drugačije javlja nego kod drugih infekcija, to je takozvana kasna komplikacija, odnosno u proseku nakon sedam godina, može doći do zapaljenja mozga, progresivnog oboljenja sa teškim posledicama i potencijalno smrtnim ishodom", navela je Ana Banko.
Navela je primer iz Šangaja iz 2015. godine kada je dete sa malim boginjama iz neznanja primljeno na dečje onkološko odeljenje i da je svih 23 dece zaraženo, pedeset odsto je imalo teške kompikacije, a svako peto dete je preminulo.
Aktuelna su dva talasa koronavirusa – iz SAD i Kine
Profesorka Banko je, govoreći o koronavirusu, navela da trenutno dolaze dva talasa tog virusa, jedan iz Amerike, koja je suštinski i dalje omikron i da se očekuje da dođe u Evropu, a sa druge strane postoji Kina i da je procena da u toj zemlji na dnevnom nivou oboleva preko milion ljudi, što, kako je rekla, znači da će iz Kine takođe biti značajan uticaj na dalju evoluciju virusa.
"Što se tiče vakcinacije, ona je preporučena za sve one koji su stari, imunosuprimirani, sa hroničnim oboljenjima, jer svaka doza vakcine, bez obzira što nije apsolutno u korelaciji sa subvarijantama koje cirkulišu, prosto podiže spremnost imunskog sistema", rekla je Ana Banko i dodala da može da se desi da broj slučajeva zaraženih koronavirusom poraste.
Kurir.rs/RTS


